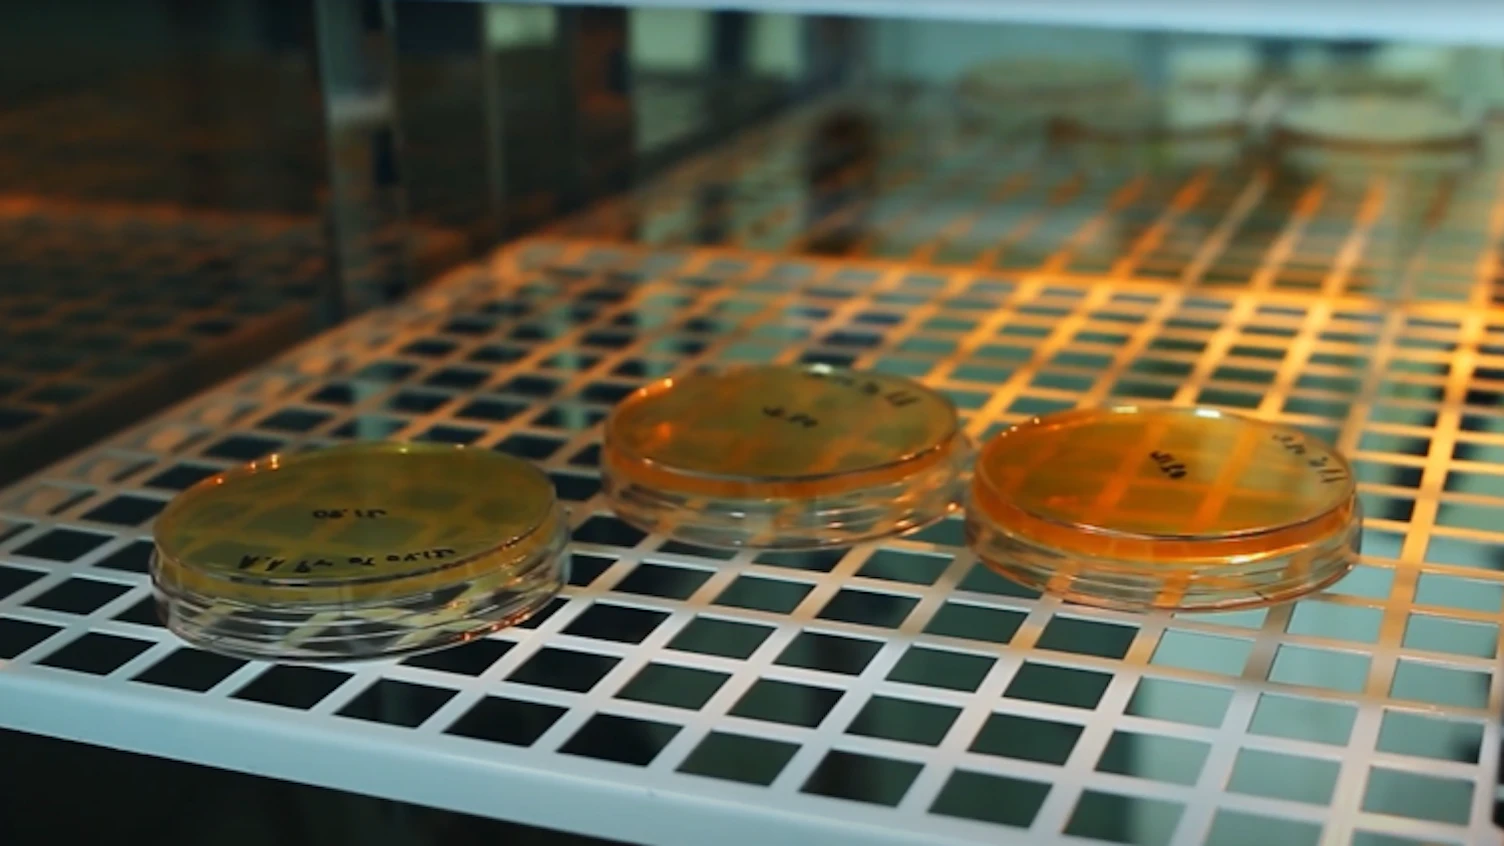
Legionella

Introducing the GBC


Discover the Cape Verde archipelago, a global biodiversity hotspot
Led by Biosphere One and with variable diversity surveys using remote underwater cameras and environmental DNA sampling, we are collecting data to determine marine life status between the islands of Wolfish to a Mile. By using powerful tools such as E-DNA, we are dedicated to helping achieve sustainability in remote and deep marine settings.

Air Sampling
Discover how our non-invasive air sampling technology uncovers the environmental DNA of the organisms that live around us. Harnessing air to explore biodiversity, we offer the very best tools for your survey.

Selvagens Islands
Explore the pristine beauty of the Selvagens Islands, a strict nature reserve in the North Atlantic. Join our scientific expedition with The Nature Conservancy to study biodiversity recovery after invasive species eradication. Our cutting-edge environmental DNA technology improves species detection and pioneers new sampling methods. Trust SGS expert analysis to help you understand and protect ecosystems throughout your sustainability journey.
Legionella
Protect your water systems from Legionella with our advanced solutions. Traditional culture-based testing is slow and biased. Our molecular and rapid diagnostic techniques provide faster results, enabling early detection and effective outbreak containment.







